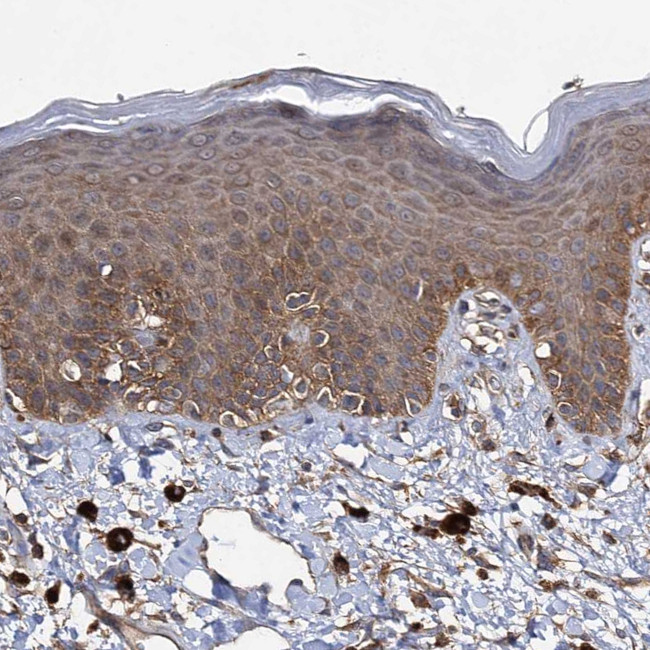
IDI1 Antibody in Immunohistochemistry (Paraffin) (IHC (P))

Search
Invitrogen
IDI1 Polyclonal Antibody
{{$productOrderCtrl.translations['antibody.pdp.commerceCard.promotion.promotions']}}
{{$productOrderCtrl.translations['antibody.pdp.commerceCard.promotion.viewpromo']}}
{{$productOrderCtrl.translations['antibody.pdp.commerceCard.promotion.promocode']}}: {{promo.promoCode}} {{promo.promoTitle}} {{promo.promoDescription}}. {{$productOrderCtrl.translations['antibody.pdp.commerceCard.promotion.learnmore']}}
产品信息
PA5-58682
种属反应
宿主/亚型
分类
类型
抗原
偶联物
形式
浓度
规格
纯化类型
保存液
内含物
保存条件
运输条件
RRID
产品详细信息
Immunogen sequence: ADCAQSGRHP GPAVVCGRRL ISVLEQIRHF VMMPEINTNH LDKQQVQLLA EMCILIDEND NKIGAETKKN
Highest antigen sequence identity to the following orthologs: Mouse - 63%, Rat - 56%.
靶标信息
IDI1 encodes a peroxisomally-localized enzyme that catalyzes the interconversion of isopentenyl diphosphate (IPP) to its highly electrophilic isomer, dimethylallyl diphosphate (DMAPP), which are the substrates for the successive reaction that results in the synthesis of farnesyl diphosphate and, ultimately, cholesterol. It has been shown in peroxisomal deficiency diseases such as Zellweger syndrome and neonatal adrenoleukodystrophy that there is reduction in IPP isomerase activity.
仅用于科研。不用于诊断过程。未经明确授权不得转售。
篇参考文献 (0)
生物信息学
蛋白别名: IPP isomerase 1; isopentenyl diphosphate dimethylallyl diphosphate isomerase 1; Isopentenyl pyrophosphate isomerase 1; Isopentenyl-diphosphate Delta-isomerase 1; unnamed protein product
基因别名: IDI1; IPP1; IPPI1
UniProt ID: (Human) Q13907
Entrez Gene ID: (Human) 3422